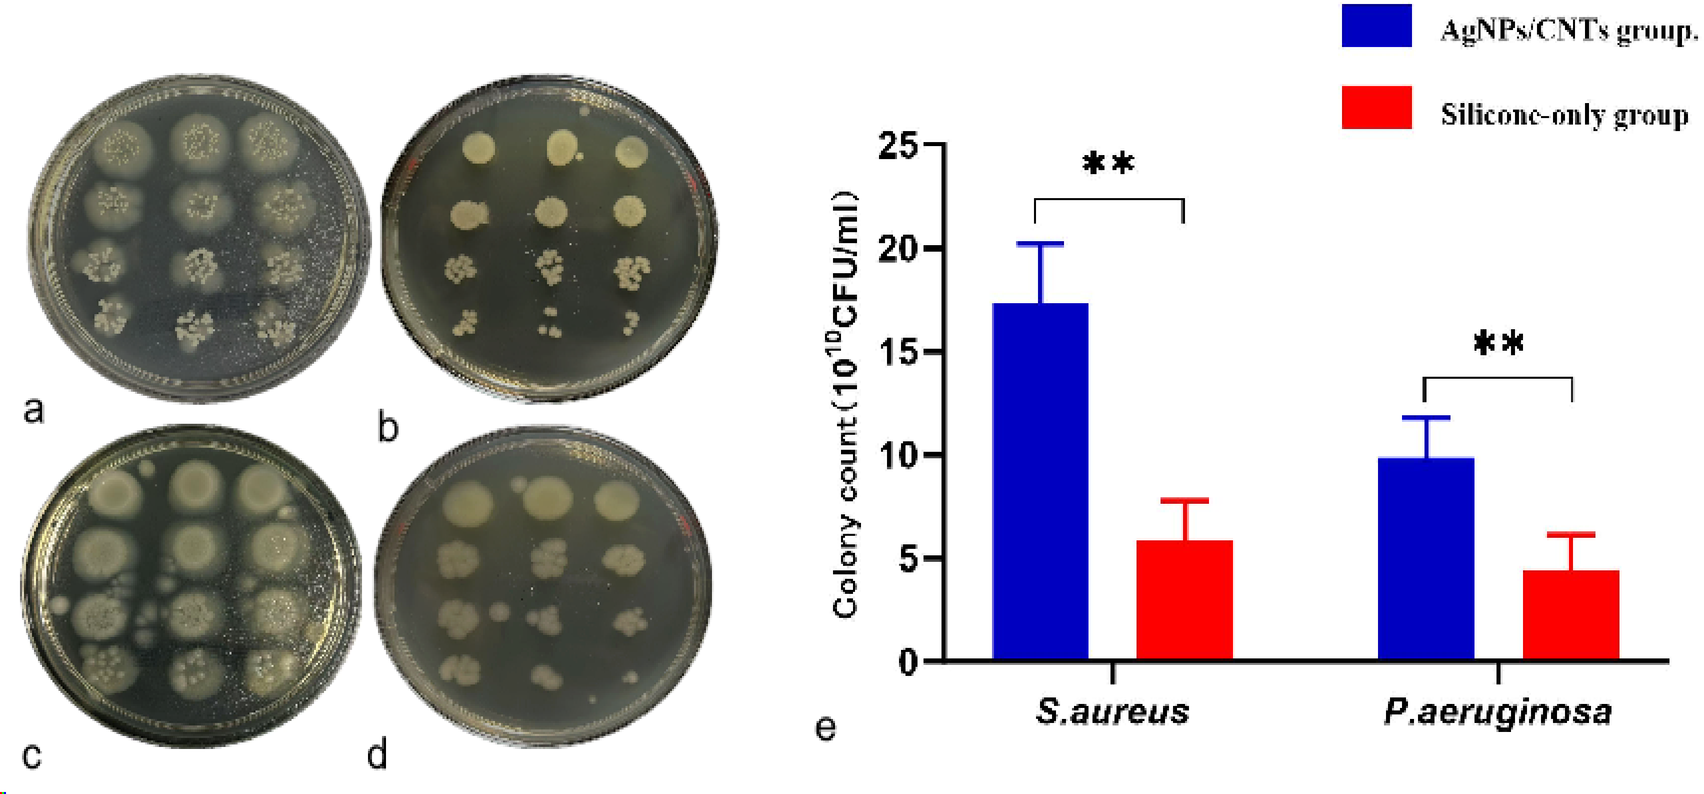
Fig. 3

Fig. 3
The in vitro colony count after co-cultivation followed by tenfold serial dilution culture. (a) After co-cultivation of Staphylococcus aureus with ordinary silicone materials, followed by tenfold serial dilution plate culture, the colony distribution is dense, and the number is relatively high; (b) After co-cultivation of Staphylococcus aureus with AgNPs/CNTs materials, followed by tenfold serial dilution plate culture, the colony distribution is sparse, and the bacterial count is relatively low; (c) After co-cultivation of Pseudomonas aeruginosa with ordinary silicone materials, followed by tenfold serial dilution plate culture, the colony distribution is dense, and the bacterial count is relatively high; (d) After co-cultivation of Pseudomonas aeruginosa with AgNPs/CNTs materials, followed by tenfold serial dilution plate culture, the colony distribution is sparse, and the bacterial count is relatively low; (e) Statistical comparison of colony numbers between the ordinary silicone group and the AgNPs/CNTs group. Note Dilution gradient to 10−8, *P < 0.05 and **P < 0.005.
